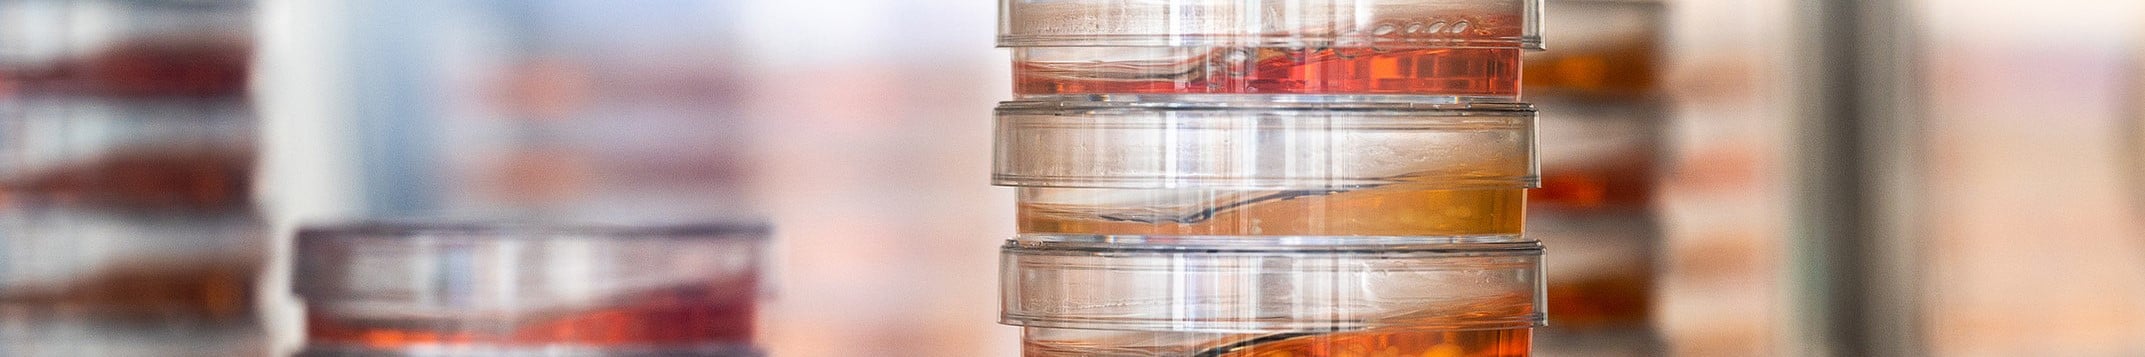

TPI initiatives
Through their initiatives, the TPI programme partners are advancing the transition to animal-free innovation. Working independently or in partnership, they are developing initiatives to accelerate the transition. The wider TPI network is also doing a great deal to accelerate the transition to animal-free innovation, not only in the Netherlands but also beyond.
Click on the tiles and discover the many activities that contribute to the Transition towards Animal-Free Innovation.